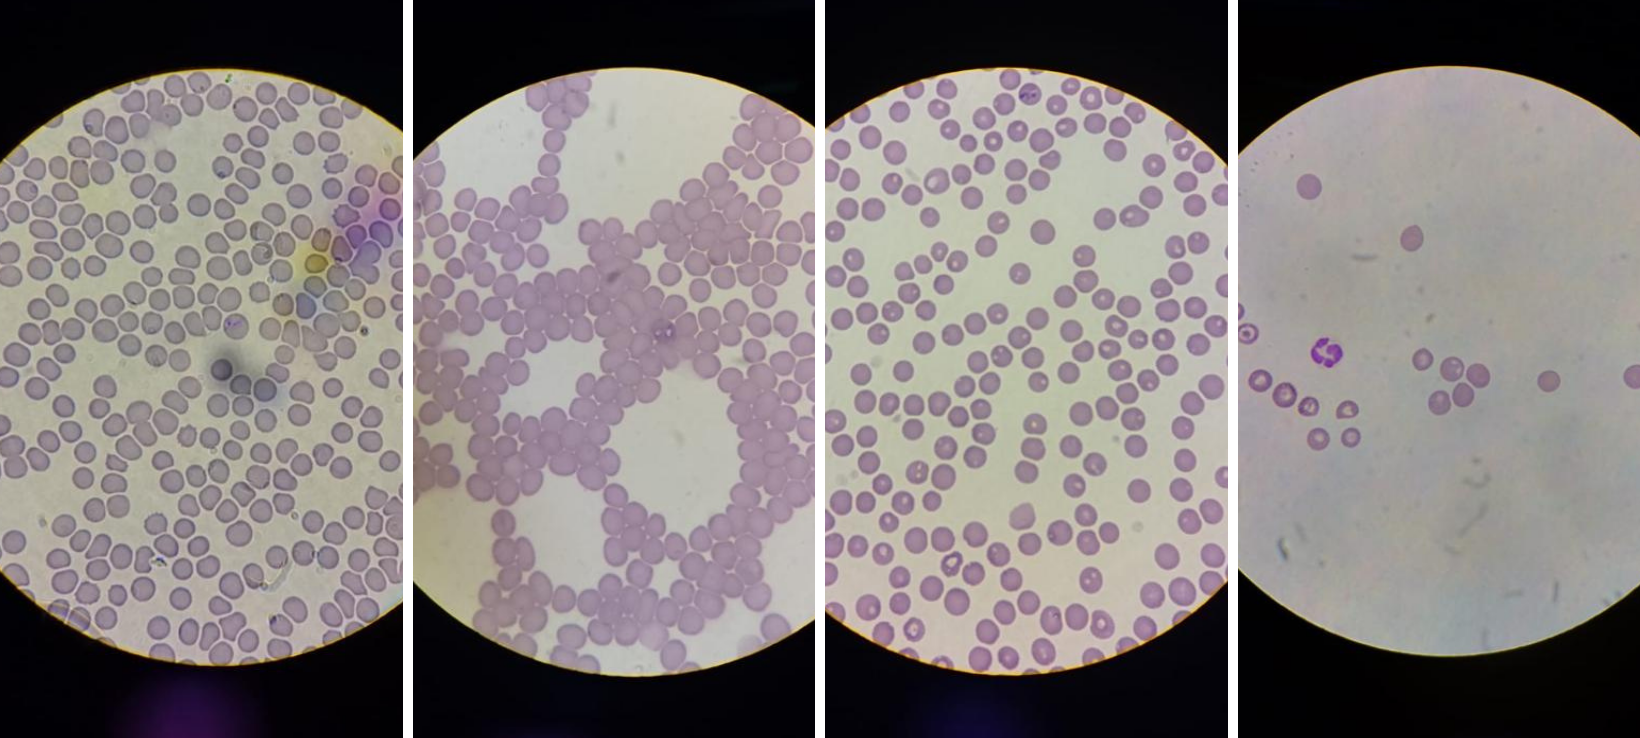

Dr. Alina Jako, medic veterinar
Babesioza este o boală parazitară, deseori fatală, distribuită pe tot globul, transmisă de înțepătura de căpușă. Afectează deopotrivă oamenii și animalele de orice vârstă. Incidența ei atinge cote alarmante când temperaturile trec de 0 grade Celsius și nu mai este considerată de multă vreme o boală sezonieră, deoarece o tratăm și în luna decembrie.
Tipurile de babesii întâlnite mai des la noi în țară sunt Babesia canis (piroplasma mare), Babesia canis rossi, Babesia gibsoni (piroplasmă mică). Însă nu toate căpușele transmit babesioza, ci doar cele care conțin acest parazit și reușesc să stea atașate de cățel 24-48 ore, de aceea dacă ați găsit o căpușă pe prietenul vostru patruped prezentaţi-vă cât mai repede la cabinetul veterinar pentru a fi detașată corect.
Babesia este un hemoparazit ce ajunge și se multiplică rapid în celulele roșii ale sângelui, distrugându-le treptat și astfel provoacă anemii severe.
SEMNELE CLINICE care ar trebui să ne trimită de urgenţă la medicul veterinar şi care apar de obicei la 6-8 zile de la inoculare sunt:
- cățelul este apatic – lipsit de energie;
- lipsa poftei de mâncare, pierdere în greutate;
- febră – 41⁰ C;
- abdomen ușor umflat (spleno- și hepatomegalie);
- urină modificată la culoare (hematuria – sânge în urină);
- mucoase palide (scade numărul de hematii, anemia hemolitică apare după ce piroplasma infectează eritrocitele, distrugându-le);
- icter (culoare galbenă, acesta se datorează bilirubinei, pigment localizat în sânge, iar atunci când eritrocitele sunt distruse de babesii, acest pigment se eliberează în tot organismul);
- hipotensiune arterială;
- modificări funcționale ale sistemului nervos central (encefalita, care poate fi fatală pentru patruped);
- semne gastro-intestinale, constipație sau diaree, cauzată de îngreunarea circulației în aceste teritorii de către eritrocitele distruse.
CUM AFECTEAZĂ ORGANISMUL
Sunt afectați toți câinii indiferent de vârstă, sex, rasă, iar riscul este reprezentat de expunerea la medii contaminate cu căpușe și o deparazitare externă defectuoasă.
Contaminarea se realizează transcutanat, atunci când căpușa se prinde de pielea animalului sau prin transfuzii de sânge.
Căpușa se hrănește cu sângele acestuia și odată cu saliva acesteia se inoculează paraziții. Ajunși în sânge aceștia trec din plasmă pe suprafața hematiilor, apoi în interiorul lor unde se hrănesc, se înmulțesc, întru-un final distrugându-le.
Hematiile infestate sunt atacate de sistemul imunitar pentru că sunt considerate agenți patogeni din cauza prezenței paraziților astfel se produce dubla distrugere a hematiilor, una este distrugerea autoimună și cealaltă este cea produsă de babesie. Acest lucru duce la o anemie severă, majoritatea câinilor necesitând transfuzii de sânge.

DIAGNOSTICUL
Se realizează prin examene de sânge și urină, prin examinarea microscopică a unui frotiu din sângele periferic, este elementară pentru diagnosticarea acestei boli grave. Pe sângele recoltat de la animalul bolnav se vor evidenția hematii distruse sau paraziți intracelulari cu aspect caracteristic.
Examenul microscopic în stadiul incipient al bolii poate fi negativ sau neconcludent. Este recomandat ca pacientul să fie supravegheat îndeaproape de către medicul veterinar curant, iar microscopia și hematologia să fie repetate în funcție de starea generală a pacientului la intervale regulate de 24-48 ore. Aceasta ne ajută să urmărim evoluția anemiei în timp pentru a putea lua decizii medicale salvatoare pentru viața pacientului (hemotransfuzie).
Este foarte important și examenul biochimic al sângelui și urinei pentru a stabili starea de funcționare a organelor interne, rinichii în special.
Recomandăm și o dozare de electroliți pentru a vedea distrugerile provocate de contactul cu babesia.
TRATAMENTUL
Se concentrează pe eliminarea parazitului și susținerea organismului cățelului. Dacă boala este identificată la debut, recuperarea poate fi completă. Există metode de tratament care s-au dovedit eficiente în suprimarea simptomelor acestei boli cu toate că infecția cu babesia poate fi persistentă chiar și după recuperare. Câinele trebuie ținut sub observație și repetate regulat testele de sânge.
Este un tratament lung, anevoios, care nu întotdeauna are succes, mai ales dacă boala este într-un stadiu avansat, terapia patrupedului este reprezentată de administrarea de unul dintre agenții antiinfecțioși în funcție de specia de babesie care a cauzat infecția.
Căpușele mai pot transmite borelioza, anaplasmoza, erhlichioza, aceste boli se localizează tot în sânge. Din fericire, beneficiem de teste rapide de diagnostic pentru ele, astfel că în 10 minute avem rezultatul.

PREVENIREA
O reprezintă deparazitările externe riguroase, 12 luni pe an. Noi recomandăm 2 metode de protecție pe același pacient: zgardă care trebuie înlocuită la fiecare 6 luni și pipeta sau comprimat antiparazitar extern lunar. O singură metodă de protecție nu mai este de ajutor.
Este necesar să verificați corpul câinelui după fiecare plimbare, căpușele preferă zonele fără păr.
Deoarece măsurile oficiale de combatere a dăunătorilor sunt foarte rare și țin până la prima ploaie, vă rugăm protejați-i pe câini de paraziți prin deparazitări externe regulate.
PROGNOSTICUL
Unui pacient diagnosticat cu babesioză este rezervat, efectele bolii pot fi devastatoare și în ciuda tratamentului de susținere animalul nu se mai poate recupera.
Un pacient care a supraviețuit bolii poate suferi o recidivă în viitor, avem cazuri în care, în același sezon, am tratat de babesioză același pacient de mai multe ori. Cei care au trecut prin boală nu mai pot fi donatori de sânge deoarece există riscul ca beneficiarul să dezvolte boala.
 Dr. PhD Alina Jako, medic veterinar Clinica TwoVet Bârlad, Doctor în Științe Medicale Veterinare – Boli Infecțioase
Dr. PhD Alina Jako, medic veterinar Clinica TwoVet Bârlad, Doctor în Științe Medicale Veterinare – Boli Infecțioase

